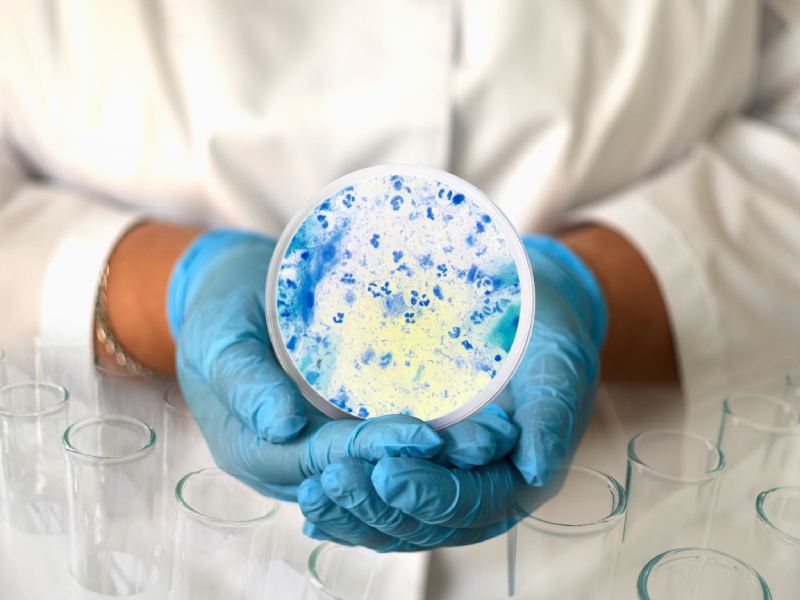
تشخیص و درمان کلامیدیا

کلامیدیا چیست؟ علائم مهم، درمان و پیشگیری

کلامیدیا از شایعترین عفونتهای مقاربتی است؛ باکتری که میتواند هم زنان و هم مردان را درگیر کند، بیآنکه علامت خاصی داشته باشد. همین ویژگی این بیماری، باعث میشود خیلیها از ابتلای خود به این بیماری مطلع نباشند و ناخواسته بیماری را منتقل کنند.
درمان کلامیدیا ساده و سریع است و با یک دوره مصرف آنتیبیوتیک، برطرف میشود. البته اگر این بیماری درمان نشود، میتواند به مشکلات جدی مثل بیماری التهابی لگن، ناباروری، بارداری خارجرحمی و حتی عوارض دوران بارداری منجر شود. به همین دلیل، تشخیص و درمان بهموقع، کلید پیشگیری از مشکلات بعدی ناشی از این بیماری است.
در این مقاله از دارو دات کام، درباره این بیماری، علائم، راههای انتقال، روشهای پیشگیری، عوارض ناشی از عدم درمان و در نهایت راههای تشخیص و درمان آن، برایتان خواهیم گفت؛ با ما همراه باشید.
کلامیدیا چیست؟
کلامیدیا (Chlamydia trachomatis)، نوعی عفونت مقاربتی (STI) شایع است و معمولا از طریق رابطه واژینال، دهانی یا مقعدی منتقل میشود.کلامیدیا میتواند بهراحتی در بدن گسترش پیدا کرده و اغلب بدون علامت باقی بماند. این باکتری برای زنده ماندن، از سلولهای بدن میزبان استفاده میکند.
این بیماری در صورت عدم درمان، منجر به ایجاد عوارض جدی مانند بیماری التهابی لگن، ناباروری، بارداری خارج رحمی و افزایش خطر ابتلا به ویروس HIV میشود. ابتلا به کلامیدیا در زنان باردار، ممکن است باعث زایمان زودرس یا تولد نوزاد با وزن پایین شود.
موثرترین روش برای پیشگیری از این بیماری، استفاده درست و مداوم از کاندوم هنگام رابطه جنسی، به شمار میرود.
کلامیدیا چقدر شایع است؟
According to the CDC, more than 1.6 million chlamydia cases were reported in 2023, but the true number is likely much higher due to the infection’s often asymptomatic nature. It is most common among young adults, with about 56% of reported cases occurring in people aged 15 to 24
طبق گزارش CDC، در سال ۲۰۲۳ بیش از ۱.۶ میلیون مورد کلامیدیا ثبت شده، اما به دلیل بیعلامت بودن بسیاری از عفونتها، تعداد واقعی بسیار بیشتر است. این عفونت بیشتر در جوانان دیده میشود و حدود ۵۶٪ موارد گزارششده مربوط به افراد ۱۵ تا ۲۴ سال بوده است. (منبع)
علائم کلامیدیا چیست؟
کلامیدیا اغلب بدون علامت است و به همین دلیل به آن عفونت خاموش نیز گفته میشود. نشانههای ابتلا به کلامیدیا به شرح زیر است:
- ترشحات غیرطبیعی از واژن یا آلت تناسلی
- احساس سوزش هنگام ادرار
- درد در ناحیه تحتانی شکم
- خونریزی بین دورههای قاعدگی یا بعد از رابطه جنسی
- درد در بیضهها
- درد هنگام رابطه جنسی
- عفونت مقعدی با علائمی مانند درد، ترشح یا خونریزی
- عفونت چشمی با قرمزی، تورم، خارش، ترشح و حساسیت به نور
کلامیدیا در صورت انتقال به چشم، علائمی مانند قرمزی، ترشح، خارش، تورم و حساسیت به نور را نیز ایجاد میکند.
علائم کلامیدیا در زنان چیست؟
زنان مبتلا به کلامیدیا، ممکن است هیچ علائمی از بیماری را نشان ندهند؛ با اینحال نشانههای کلامیدیا در زنان عبارت است از:
- ترشحات غیر طبیعی واژن
- احساس سوزش هنگام ادرار
- خونریزی بین دورههای قاعدگی یا بعد از رابطه جنسی
- درد یا ناراحتی در ناحیه زیر شکم
- خارش
- درد هنگام رابطه جنسی
- خونریزی مقعدی یا درد و ترشح در صورت ابتلا به عفونت ناحیه مقعد
علائم کلامیدیا در مردان چیست؟
مهمترین نشانههای کلامیدیا در مردان شامل موارد زیر میشود:
- ترشح سفید، کدر یا آبکی از نوک آلت تناسلی
- احساس سوزش هنگام ادرار
- درد و تورم در یک یا هر دو بیضه (شیوع کمتری دارد.)
- خارش در اطراف آلت تناسلی
- درد، ترشح یا خونریزی مقعدی
- گلودرد یا سرفه (در صورت عفونت دهانی)
- قرمزی، ترشح و خارش چشم (در صورت انتقال به چشم)
نکته! این علائم ممکن است در مراحل اولیه بیماری ظاهر نشوند. همچنین، نشانههای بیماری مقاربتی کلامیدیا براساس شدت عارضه، متفاوت خواهند بود.
اولین علائم کلامیدیا
علائم اولیه کلامیدیا ممکن است یک هفته تا چند ماه پس از تماس جنسی با فرد آلوده، ظاهر شوند. اولین نشانههای این بیماری، موراد زیر هستند:
- احساس سوزش هنگام ادرار
- ترشحات غیر طبیعی از واژن یا آلت تناسلی
- درد در ناحیه تحتانی شکم
- خونریزی بین قاعدگیها یا پس از رابطه جنسی در زنان
- ترشح یا درد در ناحیه مقعد
- گلودرد یا چشم درد بسته به محل عفونت

انواع کلامیدیا
کلامیدیا، انواع مختلفی دارد که هر کدام سلولها و بافتهای خاصی از بدن را هدف قرار میدهند. شایعترین نوع آن کلامیدیا تراکوماتیس (Chlamydia trachomatis) است که دستگاه تناسلی را درگیر میکند، اما انواع دیگری هم هستند که میتوانند چشم، ریه یا سایر بخشهای بدن را آلوده کنند.
انواع کلامیدیا را در ادامه، معرفی خواهیم کرد:
کلامیدیا تراکوماتیس
کلامیدیا تراکوماتیس، شایعترین نوع این بیماری است که از طریق رابطه جنسی منتقل میشود. این نوع از کلامیدیا، ممکن است نواحی گلو، واژن، دهانه رحم، مقعد و مجرای ادرار را در زنان آلوده کند. همچنین این بیماری منجر به آلوده شدن گلو، مقعد، آلت تناسلی و مجرای ادرار در مردان میشود.
کلامیدیا تراکوماتیس هنگام زایمان از مادر به نوزاد منتقل میشود و باعث عفونت چشمی در نوزاد خواهد شد.
کلامیدیا پنومونیه
عامل شایع ذاتالریه در سراسر جهان است. این کلامیدیا ممکن است با بیماریهایی مانند آرتریت، آسم، سرطان و بیماری قلبی مرتبط باشد.
کلامیدیوفیلا پسیتاسی
این نوع از کلامیدیا از طریق استنشاق، تماس فیزیکی یا بلع از پرندگان و حیوانات منتقل میشود. علائم کلامیدیوفیلا پسیتاسی در ابتدا شبیه به آنفولانزا است.
کلامیدیا چگونه منتقل میشود؟
در بیشتر موارد این بیماری، از طریق تماس جنسی و از طریق رابطه واژینال، مقعدی یا دهانی با فرد آلوده،منتقل میشود. البته راههای انتقال این بیماری، محدود به رابطه جنسی کامل، نیست؛ حتی تماس سطحی با اندام تناسلی، بدون دخول نیز احتمال ابتلا را بالا میبرد.
برای مثال اگر کسی بعد از تماس با اندام تناسلی و بدون شستن دست، چشم خود را لمس کند، ممکن است به این بیماری مبتلا شود.
کلامیدیا از طریق راههای زیر، منتقل نخواهد شد:
این دسته از فعالیتهای جنسی، کلامیدیا را انتقال نمیدهند:
- بوسیدن
- در آغوش گرفتن یا دست دادن
- استفاده از سرویس بهداشتی پس از فرد دیگر
- در معرض سرفه یا عطسه شخص دیگری بودن
آیا میتوان بدون رابطه جنسی به کلامیدیا مبتلا شد؟
کلامیدیا در بیشتر موارد از طریق رابطه جنسی منتقل میشود. البته در برخی شرایط خاص نیز این بیماری ممکن است بدون برقراری رابطه جنسی کامل نیز منتقل شود که در ادامه بررسی میکنیم.
- تماس جنسی بدون دخول: احتمال انتقال بیماری مقاربتی بر اثر تماس با مایعات آلوده بدن مانند پیشاب یا منی، وجود دارد.
همسرم کلامیدیا ندارد، چطور به آن مبتلا شدهام؟
بیشتر افراد مبتلا به کلامیدیا یا سوزاک، علائمی ندارند؛ با اینحال فردی که تست او مثبت شده است، احتمال دارد این عفونت را از رابطه قبلی در گذشته گرفته باشد. انتقال عفونتهای مقاربتی در هر بار رابطه جنسی، همیشه صد درصد نیست. انتقال بیماریهای مقاربتی بر اثر رابطه جنسی به نحوه رعایت بهداشت رابطه، بستگی دارد.
عوارض کلامیدیا برای زنان و مردان چیست؟
کلامیدیا در صورت درمان نشدن، ممکن است سلامت بیمار را به خطر بیندازد. عدم درمان این بیماری، احتمال ابتلا به عوارض مختلفی از جمله آرتریت واکنشی و ریسک ابتلا به HIV در زنان و مردان را افزایش میدهد.
همچنین ممکن است منجر به بروز عوارضی شود که بسته به جنسیت متفاوت بوده و در ادامه آنها را بررسی میکنیم.
عوارض کلامیدیا در زنان
عوارض احتمالی کلامیدیا در زنان به ترتیب زیر خواهد بود:
- بیماری التهابی لگن (PID)؛ این بیماری زمانی رخ میدهد که عفونت درماننشدهای مانند کلامیدیا به اندامهای تولیدمثلی آسیب بزند.
- عوارض بارداری؛ عفونت درماننشده ممکن است باعث زایمان زودرس شود.
- انتقال بیماری به جنین؛ اگر در دوران بارداری به کلامیدیا مبتلا باشید، ممکن است آن را به نوزاد خود نیز منتقل کنید.
- ناباروری؛ عفونت درماننشده کلامیدیا در مواردی به لولههای فالوپ، رحم یا واژن آسیب میرساند و باردار شدن را دشوار یا غیرممکن خواهد کرد.
عوارض کلامیدیا در مردان
عوارض کلامیدیا در مردان شامل موارد زیر میشود:
- اپیدیدیمیت: باعث درد، تورم و حساسیت بیضهها میشود.
- کاهش باروری: کلامیدیا ممکن است به اسپرم آسیب برساند و توانایی باروری را کاهش دهد.
کلامیدیا چگونه تشخیص داده میشود؟
پزشک عمومی، متخصص زنان و متخصص اورولوژی در مرحله اول از تشخیص کلامیدیا، معاینه فیزیکی انجام میدهد تا ترشحات و زخمها را بررسی کند.
سپس پزشک ممکن است نمونهای از ناحیه مشکوک مثل واژن، مجرای ادراری، مقعد یا گلو با سواب بگیرد. همچنین بر اساس تشخیص پزشک، نمونه ادرار برای بررسی وجود باکتری دریافت خواهد شد. رایجترین و دقیقترین آزمایش تشخیص کلامیدیا، آزمایش تقویت اسید نوکلئیک (NAAT) است.
نوع نمونهگیری از واژن یا مجاری اداری، بستگی به شیوه روابط جنسی و سابقه پزشکی فرد دارد. برای برخی افراد، مانند زنان باردار و افراد زیر ۲۵ سال، اجرای آزمایشهای غربالگری دورهای اهمیت دارد.
در صورت وجود عفونت کلامیدیا یا ترشحات واژینال در بیمار، انجام آزمایش برای سایر عفونتهای مقاربتی مانند HIV، سفلیس و سوزاک نیز توصیه میشود.
نکته مهم! ممکن است پزشک، تنها براساس شرح حال شما و یافتههای معاینه، درمان را برای شما شروع کند.
هر چند وقت یکبار باید آزمایش کلامیدیا را تکرار کرد؟
اگر رابطه جنسی ایمن داشته و سابقهی ابتلا به عفونت مقاربتی را ندارید، توصیه میکنیم سالی یک بار آزمایش تشخیص کلامیدیا را انجام دهید. اگر فکر میکنید رابطه جنسی پرخطر داشتهاید، توصیه میشود هر ۳ تا ۶ ماه یکبار، آزمایش کلامیدیا را انجام دهید.
توجه داشته باشید که برای آزمایش کلامیدیا باید حداقل ۱۴ روز پس از رابطه جنسی محافظتنشده اقدام کنید.
آیا کلامیدیا قابل درمان است؟
بله. کلامیدیا قابل درمان است. با اینحال برخی از عفونتهای مقاربتی در حال مقاوم شدن نسبت به آنتیبیوتیکها هستند؛ این موضوع درمان انواع عفونتهای مقاربتی را نیز دشوارتر میکند. باتوجه به این موضوع، بهترین راه مقابله با این بیماری، پیشگیری از گسترش عفونت است.
کلامیدیا چگونه درمان میشود؟
درمان کلامیدیا، ترکیبی از مصرف قرصهای آنتیبیوتیک، مراقبتهای بهداشتی و انجام آزمایشهای مختلف است. روشهای درمان این بیماری، شامل موارد زیر میشود:
- پرهیز از فعالیتهای جنسی پرخطر در طول ناقل بودن بیماری
- مصرف داروهای تجویز شده توسط پزشک
- انجام آزمایشهای لازم برای اطمینان از درمان کامل عفونت
در صورت مشاهده اولین نشانههای کلامیدیا، برای درمان سریع و موثر بیمار به پزشک مراجعه کنید.
بهترین قرص برای کلامیدیا
بر اساس تجربه بیماران و تجویز پزشکان، بهترین قرصها برای درمان کلامیدیا، شامل موارد زیر میشوند:
- داکسی سایکلین
- آزیترومایسین
- آموکسی سیلین
- اریترومایسین
نکته! این قرصها، فقط باید با تجویز پزشک مصرف شوند. همچنین مهم است که دوره درمان خود را تکمیل کنید حتی اگر علائمتان بهبود پیدا کرده باشد.
تغییر در سبک زندگی
بخشی از درمان کلامیدیا، اصلاح سبک زندگی است:
- تا زمانی که عفونت کاملا برطرف نشده، از برقراری رابطه جنسی خودداری کنید.
- تمامی شرکای جنسی خود در 3 ماه گذشته را مطلع کنید تا آنها نیز آزمایش دهند.
- آزمایش دیگر بیماریهای مقاربتی مانند HIV، سیفلیس، سوزاک و تبخال را انجام دهید.
آیا کلامیدیا میتواند بهخودی خود از بین برود؟
کلامیدیا خودبهخود از بین نمیرود. برای درمان کامل این بیماری حتما باید به پزشک مراجعه کرده و براساس تجویز پزشک به مصرف آنتیبیوتیک اقدام کنید. همچنین اگر از نظر جنسی فعال هستید، این خطر وجود دارد که دیگران را نیز آلوده کنید.
آیا درمان سوزاک و کلامیدیا شبیه هم است؟
درمان کلامیدیا و سوزاک با آنتیبیوتیکهای متفاوتی انجام میشود؛ زیرا توسط باکتریهای متفاوتی ایجاد میشوند.
درمان کلامیدیا چه مدت طول میکشد؟
با شروع درمان، علائم کلامیدیا معمولا حدود یک هفته پس از شروع مصرف آنتیبیوتیکها، بهبود پیدا میکنند. البته ممکن است نتیجه آزمایش تا ۴ هفته پس از درمان نیز همچنان مثبت باقی بماند.
توجه داشته باشید که تا حداقل هفت روز بعد از شروع درمان کلامیدیا، از هرگونه رابطه جنسی خودداری کنید. این زمان، به دارو فرصت میدهد تا اثر کند و از انتقال عفونت به شریک جنسی نیز جلوگیری شود.
پس از پایان درمان نیز، همچنان رابطه جنسی ایمن داشته باشید و بهعنوان بخشی از مراقبتهای بهداشتی خود، غربالگریها و آزمایشهای لازم را انجام دهید.
چطور میتوان از کلامیدیا پیشگیری کرد؟
برای پیشگیری از ابتلا به این بیماری باید به بایدها و نبایدهایی که در ادامه بررسی میکنیم، توجه داشته باشید.
بایدها و نبایدهای لازم برای پیشگیری از بیماری کلامیدیا
- هنگام رابطهی واژینال یا مقعدی از کاندوم استفاده کنید.
- هنگام رابطهی دهانی، برای پوشاندن آلت تناسلی از کاندوم یا برای پوشاندن واژن از پوشش لاتکسی یا پلاستیکی (دام) استفاده کنید.
- با فواصلی که پزشکتان برایتان معین میکند، آزمایشهای لازم برای تشخیص بیماریهای مقابتی را انجام دهید.
- رابطه جنسی بدون کاندوم برقرار نکنید.
چه زمانی باید به پزشک مراجعه کنم؟
در صورت مشاهده هرگونه ترشح از واژن، آلت تناسلی یا مقعد به پزشک عمومی یا متخصص مراجعه کنید. همچنین اگر هنگام ادرار کردن احساس درد میکنید نیز باید به پزشک عمومی مراجعه بفرمایید. علاوهبر این مواد، اگر متوجه شدید که شریک جنسیتان به کلامیدیا مبتلا است، حتما به پزشک مراجعه کنید.
به چه پزشکی باید برای درمان کلامیدیا مراجعه کنم؟
برای تشخیص نوع بیماری مقاربتی در مرحله اولیه میتوانید به پزشک عمومی مراجعه کنید. در نهایت، برای تشخیص و درمان دقیقتر این بیماری به متخصص اورولوژی یا زنان برای بانوان و برای آقایان، به اورولوژیست یا پزشک متخصص بیماریهای مقاربتی مراجعه کنید.
توصیهای از تیم دارو دات کام به شما
انجام غربالگری منظم برای تشخیص بهموقع کلامیدیا و سایر بیماریهای مقاربتی، اهمیت ویژه دارد؛ اهمیت این کار را دست کن نگیرید. در ضمن، رعایت نکات مراقبتی و بهداشتی را هنگام برقراری ارتباط جنسی، در اولویت قرار دهید.
اگر سوالی دارید، در بخش نظرات بنویسید و با ما به اشتراک بگذارید.






























